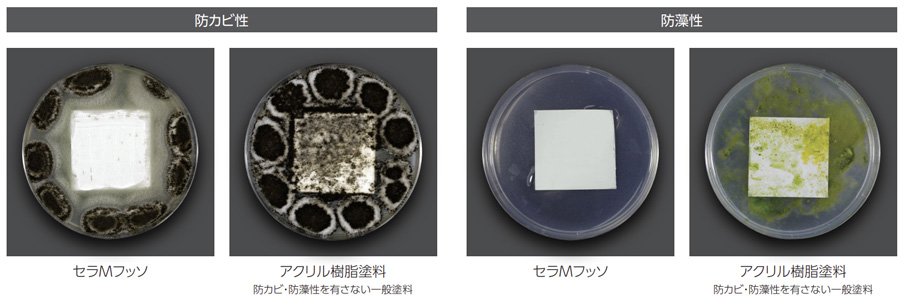

佐藤和幸
セラMフッソは、耐久性の高いセラミック変性フッ素樹脂で建築物や鋼構造物を保護し、さらに臭気が少なく環境にも優しい塗料です。また、耐候性や耐汚染性、防カビ・防藻性にも優れています。
従来のウレタン樹脂やアクリルシリコン樹脂系塗料に比べて耐久性が高いため、長期的なメンテナンスコストが抑えられ、資産価値の向上と大きなコストメリットにも繋がります。
仕上りは肉持ち感のある塗膜になり、幅広い素材や旧塗膜に対応しています。
セラMフッソとは

セラMフッソは、関西ペイントが開発した高耐候・高耐久な2液弱溶剤形ふっ素樹脂塗料です。
関西ペイントは、創業100年以上の歴史を持つ日本を代表する塗料メーカーで、住宅から大型建築物、さらには自動車や産業分野まで、幅広い分野で採用されている信頼性の高いブランドです。
その長い歴史で培った確かな実績と技術力からも、戸建て住宅でも安心して住まいを守れる塗料として多くの方に選ばれています。
セラMフッソは、建物や鉄骨構造物をしっかりと保護しながら、施工時の臭気が少なく、周囲や住む人への配慮が行き届いている設計が特徴です。
また、防カビ・防藻性にも優れており、外壁の美しさを長期間保つことで、住まいの資産価値もしっかりと守ることができます。
セラMフッソの特長
非常に優れた耐候性・耐汚染性

セラMフッソは、JIS K 5658 1級の物性試験に合格しており、建築用仕上塗材の厳しい基準をクリアした信頼性の高い塗料です。
耐久性の高いセラミック変性ふっ素樹脂が採用されたことで、耐候性に優れた塗膜を形成し強い紫外線や雨風などの劣化要因から外壁をしっかりと守ります。
さらに、親水性の高い低汚染形セラミック変性塗膜により、汚れが付着したとしても、雨水が塗膜になじんで汚れの下に入り込み、自然に洗い流してくれるため、外壁の清潔感を長く保つことができます。
幅広い下地対応力

セラMフッソは、コンクリートやモルタル、窯業系サイディング、木部、鉄部、アルミ、亜鉛めっきなど多彩な素材に幅広く対応しています。
そのため、外壁はもちろん、素材の異なる部分や細部にも対応できるため、戸建て住宅から集合住宅や商業施設などあらゆる規模の建築物で活用することができます。
美しい仕上がりと塗膜感
 セラMフッソは、肉厚感のある塗膜を形成するため、優れた光沢が高級感のある外観を演出してくれます。さらに、塗装作業性にも優れているため、ムラなく均一な塗装が可能です。
セラMフッソは、肉厚感のある塗膜を形成するため、優れた光沢が高級感のある外観を演出してくれます。さらに、塗装作業性にも優れているため、ムラなく均一な塗装が可能です。
また、艶は「艶有り、7分艶、5分艶、3分艶」の4種類から調整が可能です。
防カビ・防藻性
セラMフッソは、塗膜に防カビ・防藻性能を備えており、湿気や汚れに強いのが特長です。
外壁の清潔さと耐久性を長期間保つ効果が期待できるので、特に湿気の多い地域や北側の壁面など、カビや藻の発生が気になる箇所に最適です。
環境や安全面への配慮

セラMフッソは、塗料などから発散されるホルムアルデヒドの量を表す等級では最高等級のF☆☆☆☆を取得している、人や環境に優しい安心設計の塗料です。
施工中の臭いも少ないので、作業員や近隣への負担も軽減することができます。
優れたライフサイクルコスト
 セラMフッソの耐用年数は約12〜15年で、従来のウレタン系塗料(約8〜10年)やアクリルシリコン系塗料(約10〜12年)を上回ります。
セラMフッソの耐用年数は約12〜15年で、従来のウレタン系塗料(約8〜10年)やアクリルシリコン系塗料(約10〜12年)を上回ります。
これにより、塗り替え回数を減らすことができるので、長期的に見るとメンテナンスコストを大幅に削減でき、建物の資産価値の維持や向上にも貢献します。
製品ラインナップ
セラMシリーズは、用途や求められる耐久性能に応じて選べる3種類の樹脂タイプと、それぞれに「標準タイプ」と「弾性タイプ」が用意されています。
それぞれの特徴は以下の通りです。
| 製品名 | 設計価格 (/㎡) |
特徴 |
|---|---|---|
| セラMレタン | 2,860円 | ウレタン樹脂が採用されており、シリーズの中で最もコストを抑えた塗料です。その分耐用年数などの性能はやや低めです。 |
| セラMレタン弾性 | 2,910円 | セラMレタンに弾性機能を加えることで、細微なひび割れにも柔軟に対応可能なため、クラックのある下地にも安心して使用できます。 |
| セラMシリコンⅢ | 3,140円 | セラミック変性シリコン樹脂の採用により、超低汚染性と高い耐候性を兼ね備え、コストと性能のバランスに優れた塗料です。 |
| セラMシリコンⅢ弾性 | 3,190円 | セラMシリコンⅢの性能に加え、柔軟性を持たせてひび割れ追従性を高めた高機能タイプの塗料です。 |
| セラMフッソ | 3,970円 | フッ樹脂を採用し、最も優れた耐候性と長期耐久性を発揮するハイグレード使用の塗料です。 |
| セラMフッソ弾性 | 4,020円 | フッ素樹脂に弾性を付加し、高耐候性とクラック追従性を両立した長寿命型の塗料です。 |
まとめ
セラMフッソは、耐久性の高いセラミック変性ふっ素樹脂を採用した高性能塗料です。紫外線や雨風から建物を守り、低汚染性や防カビ・防藻性により、外壁の美しさを長期間維持します。
戸建て住宅から集合住宅、商業施設まで幅広く対応可能で、住まいを美しく保ちながらメンテナンスコストの削減にもつながります。
外壁をご検討の際には、ぜひ佐藤塗装までお気軽にご相談ください。経験豊富なスタッフが最適なプランをご提案させていただきます。



























 お気軽に
お気軽に








 満足度96.0%!
満足度96.0%!














